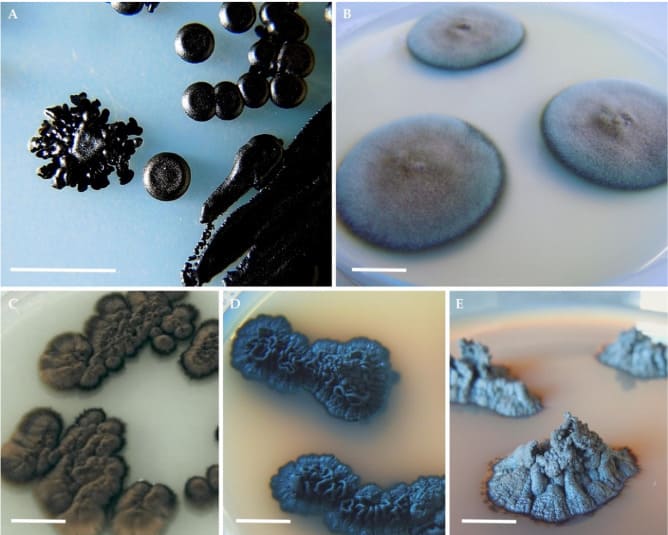
image

5 Ways Your Dishwasher is Making You Feel Unwell
Are you concerned about your health? Or have you maybe ever fallen mysteriously ill, when everything in your environment seemed to be fine? If you’d like to protect yourself from mold, bacteria and everything else that might be affecting your health, this might be the most important article you’ll read this week.

Are you cleaning your dishwasher once a month?
Even if you are, your dishwasher is way more disgusting than it seems.
Dishwashers hold on to chunks of old food, grease, and water minerals. This build-up leads to nasty smells and makes your dishes come out of the dishwasher with spots and film.
Although this is gross, something worse might be rotting in your dishwasher. Did you know that your dishwasher can harbor billions of bacteria and grow mold? This bacteria and mold could be getting you and your family members feel unwell.
The dishwasher is a damp and dark environment that is the perfect place for mold and bacteria to thrive. The mold and bacteria can get on your glassware and plates every time you use the dishwasher.
This can spread pathogens throughout your home and affect you and your family.
Let us take a closer look at how your dishwasher be making you feel unwell.
5 Ways Your Dishwasher is Making You Feel Unwell
The types of bacteria and mold that can grow inside your dishwasher should be a significant concern. Especially if you have someone in your family living with a weakened immune system.
1. Black Yeast can infect your sinuses and lungs
Breathing in the spores from Black Yeast can lead to chronic lung and sinus issues that never seem to go away. Black Yeast loves to hide in the rubber seals of dishwasher doors. It multiplies and grows in the hot and moist environment that dishwashers provide.
Tesei, D. Black Fungi Research: Out-of-This-World Implications. Encyclopedia 2022, 2, 212-229.1
Also, your dishwasher detergent could be making it worse. Many dishwasher detergents contain salt. Salt is something that yeasts thrive on.
Black Yeast can be troublesome for anybody. But, people with sensitive immune systems can be at even higher risk.
2. Red & White Yeasts can cause infections throughout the body
Besides Black Yeast, Red and White Yeast can also grow inside an unclean dishwasher2. These types of yeast can cause various other types of illnesses. Red Yeast can cause skin infections and some lung infections. Also, there is a slight chance of infection in the brain, spinal cord, eyes, stomach, and joints3.
White Yeast is a common cause of yeast infections that can affect different body parts4.
You could see white patches form in your mouth and spread to your throat and stomach. Women can also experience vaginal yeast infections. Yeast infections are generally harmless. But if they go untreated and the infection spreads to the bloodstream, it could be fatal.

White yeast causing yeast infection of the mouth: James Heilman, MD, CC BY-SA 3.0 via Wikimedia Commons5
People with suppressed immune systems or who are on antibiotics are at greater risk.
3. Bacteria that cause E. Coli
Dishwashers can create an environment where E. Coli can multiply. People who get E. Coli experience diarrhea, stomach cramping, and stomach pain. Sometimes more severe cases can cause nausea and vomiting.
Healthy adults can recover from E. Coli within a week.
4. Bacteria that cause Pneumonia, Urinary Tract Infections, and Meningitis
Another form of bacteria that can form in dishwashers can lead to illnesses - like Pneumonia, Urinary Tract Infections, and Meningitis6.
- Pneumonia: an infection that inflames air sacs in one or both lungs. The illness can cause fluid to build up in the lungs. Common symptoms include coughing, fever, chills, and breathing difficulties.
- Urinary Tract Infections: bladder, urethra, and kidney infections. Symptoms include frequent urination, burning during urination, and pelvic pain in women.
- Meningitis: an infection that causes inflammation around the brain and spinal cord. This infection needs treatment right away, or it could be fatal.

5. Bacteria that cause infections in the blood and lungs
The last common form of dishwasher bacteria can cause mild to severe infections. The infections occur in the blood or lungs. This type of bacteria can be difficult to treat because it has antibiotic resistance.
How to get rid of bacteria and mold in your dishwasher
Although some dishwashers may advertise that they are self-cleaning, are they? These self-cleaning functions are not enough to ensure your family is safe. Harmful bacteria and mold could still be able to grow in your dishwasher.

Luckily there is a tablet you only need to use once a month.
A tablet that deep cleans your dishwasher without you having to scrub it.
One tablet to keep you and your family more protected against the various diseases brought upon by dishwasher mold, yeast, and bacteria.
And it’s called Fuugu.

Run one wash cycle with one of the Fuugu Dishwasher Cleaner Tablets and kill all the bacteria and mold at once.
After one wash cycle, every part of the dishwasher will be cleaned. All parts of the dishwasher, visible and hidden, will be pristine.
So, if you are still relying on your dishwasher’s self-cleaning cycle, or you are running a wash cycle with a little bit of vinegar - you could still risk exposing yourself and your family to the dangers of a dirty dishwasher.
Why get Fuugu
Still undecided about Fuugu Dishwasher Cleaner Tablets?

Here are a few ways they can help you improve your life:
- Cleans what you can't see: your machine's tub, racks, pump and valve, drain and recirculation hoses. Thoroughly cleans the filter, hidden parts, spray arms, pumps and hidden or vital parts;
- Keeps your machine sparkly;
- Works in all sizes and types of dishwashers;
- Powers away limescale and mineral buildup;
- Easy to use tablets;
- Removes hard water stains from your glass dishes and cutlery (as well as the insides of the dishwasher);
- Fuugu tablets are biodegradable.
LIMITED TIME OFFER FOR OUR READERS: CLICK HERE FOR 70% OFF
Get 70% OFF Fuugu today! ➢1 Black Fungi Research: Out-of-This-World Implications
2 Dishwashers are a major source of human opportunistic yeast-like fungi in indoor environments in Mersin, Turkey
3 Rhodotorula infection. A systematic review of 128 cases from literature
4 Candida parapsilosis, an Emerging Fungal Pathogen - PMC
5 https://commons.wikimedia.org/wiki/File:Human_tongue_infected_with_oral_candidiasis.jpg
6 The dishwasher rubber seal acts as a reservoir of bacteria in the home environment, Acinetobacter spp. as nosocomial pathogens: Epidemiology and resistance features - PMC
This is an advertisement and not an actual news article, blog, or consumer protection update
MARKETING DISCLOSURE: This website is a market place. As such you should know that the owner has a monetary connection to the product and services advertised on the site. The owner receives payment whenever a qualified lead is referred but that is the extent of it.
ADVERTISING DISCLOSURE: This website and the products & services referred to on the site are advertising marketplaces. This website is an advertisement and not a news publication. Any photographs of persons used on this site are models. The owner of this site and of the products and services referred to on this site only provides a service where consumers can obtain and compare.
 2026-03-10
2026-03-10